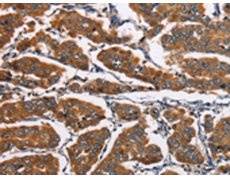
一抗

|
Background: |
This gene encodes a member of the eukaryotic translation initiation factor 4E binding protein family. The gene products of this family bind eIF4E and inhibit translation initiation. However, insulin and other growth factors can release this inhibition via a phosphorylation-dependent disruption of their binding to eIF4E. Regulation of protein production through these gene products have been implicated in cell proliferation, cell differentiation and viral infection. |
|
Applications: |
ELISA, IHC |
|
Name of antibody: |
EIF4EBP2 |
|
Immunogen: |
Fusion protein of human EIF4EBP2 |
|
Full name: |
eukaryotic translation initiation factor 4E binding protein 2 |
|
Synonyms: |
4EBP2; PHASII |
|
SwissProt: |
Q13542 |
|
ELISA Recommended dilution: |
1000-2000 |
|
IHC positive control: |
Human breast cancer and human thyroid cancer |
|
IHC Recommend dilution: |
25-100 |

 購物車
購物車 幫助
幫助
 021-54845833/15800441009
021-54845833/15800441009